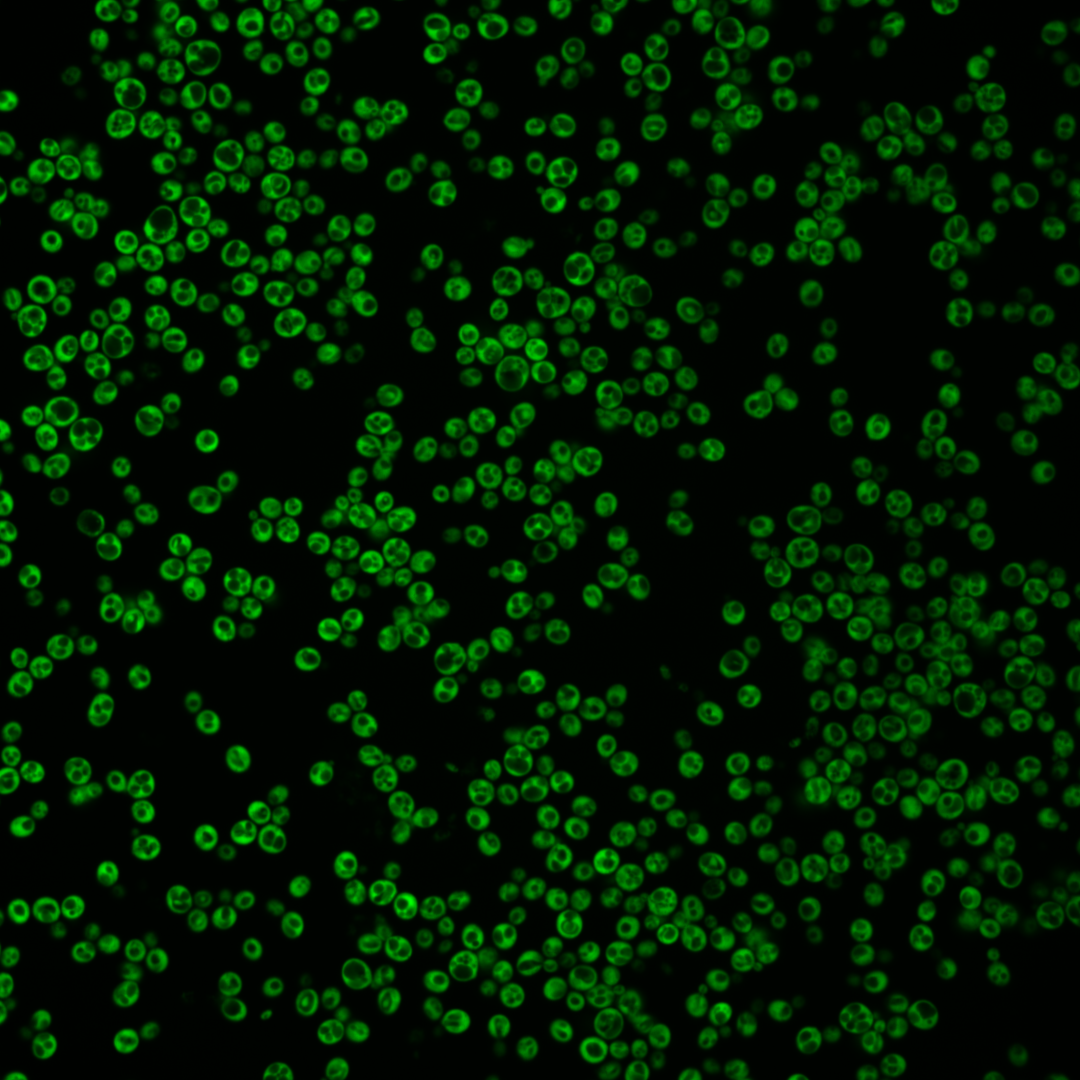
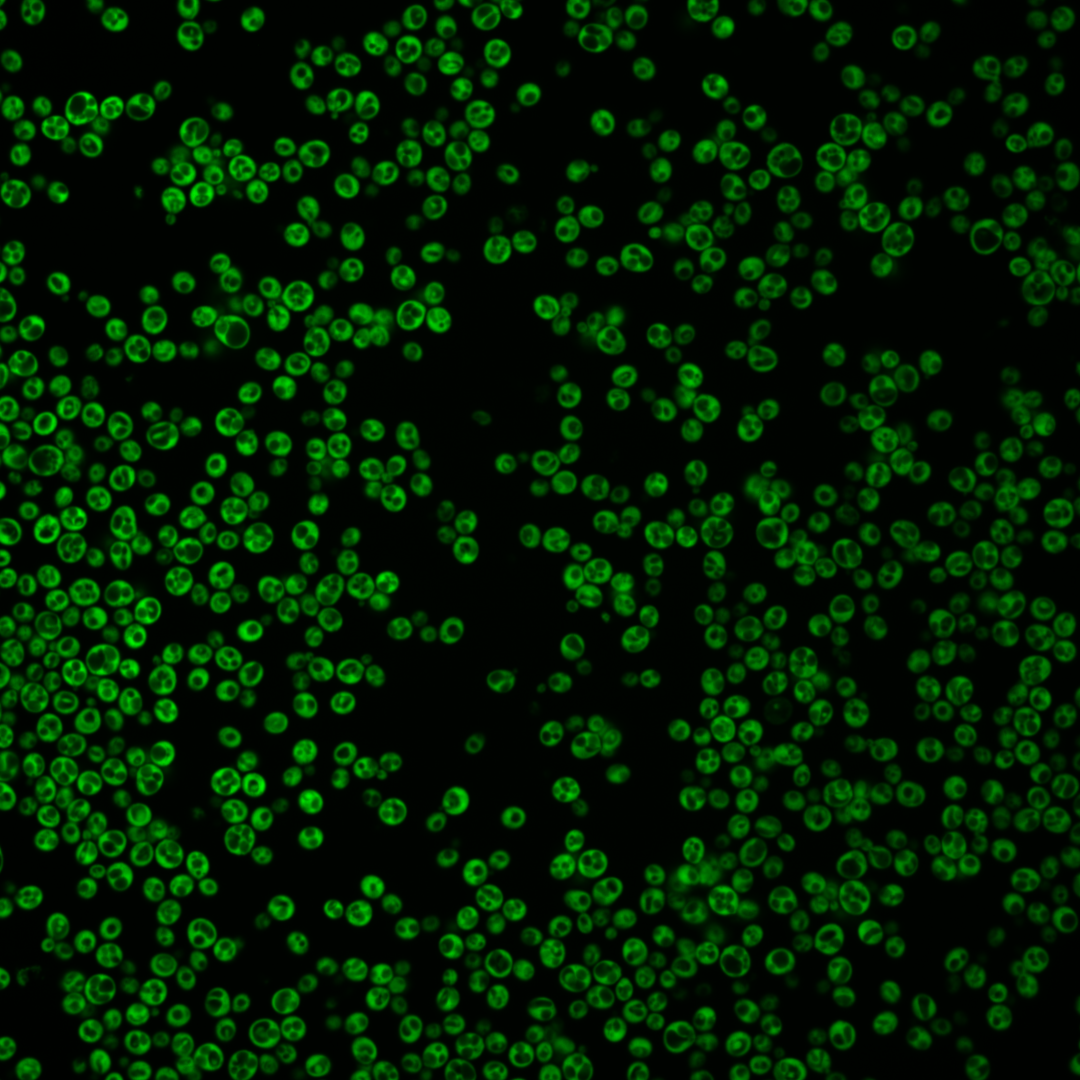
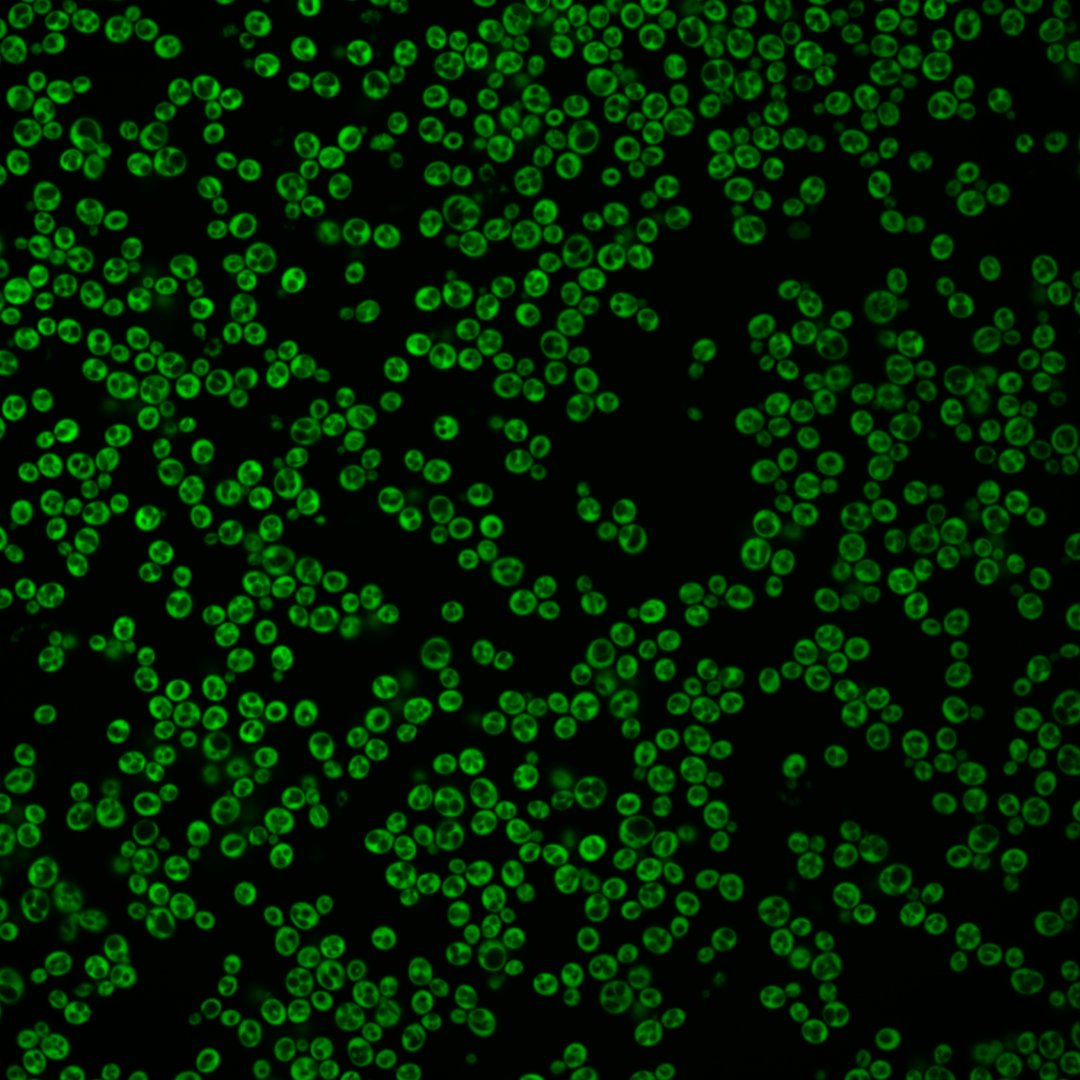
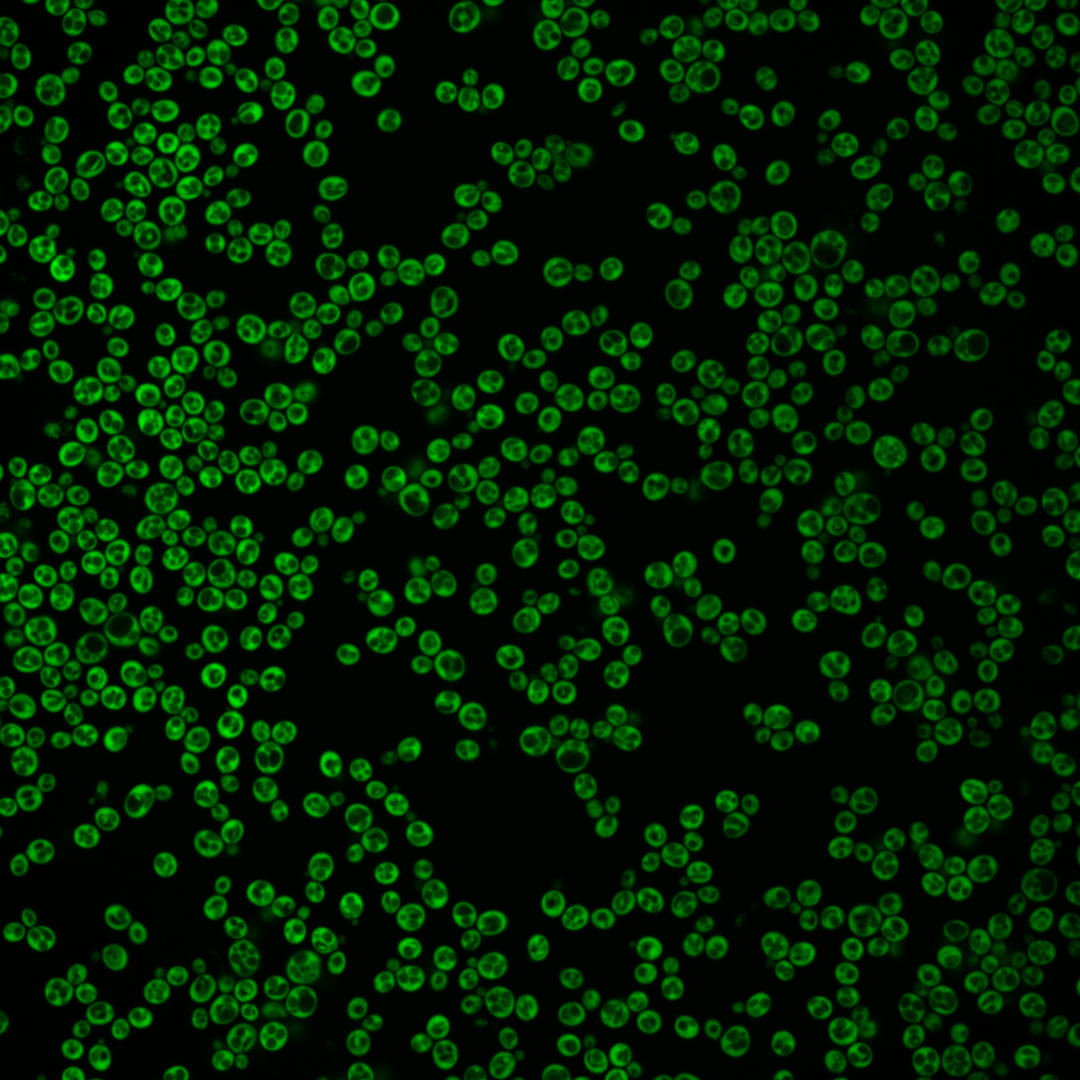
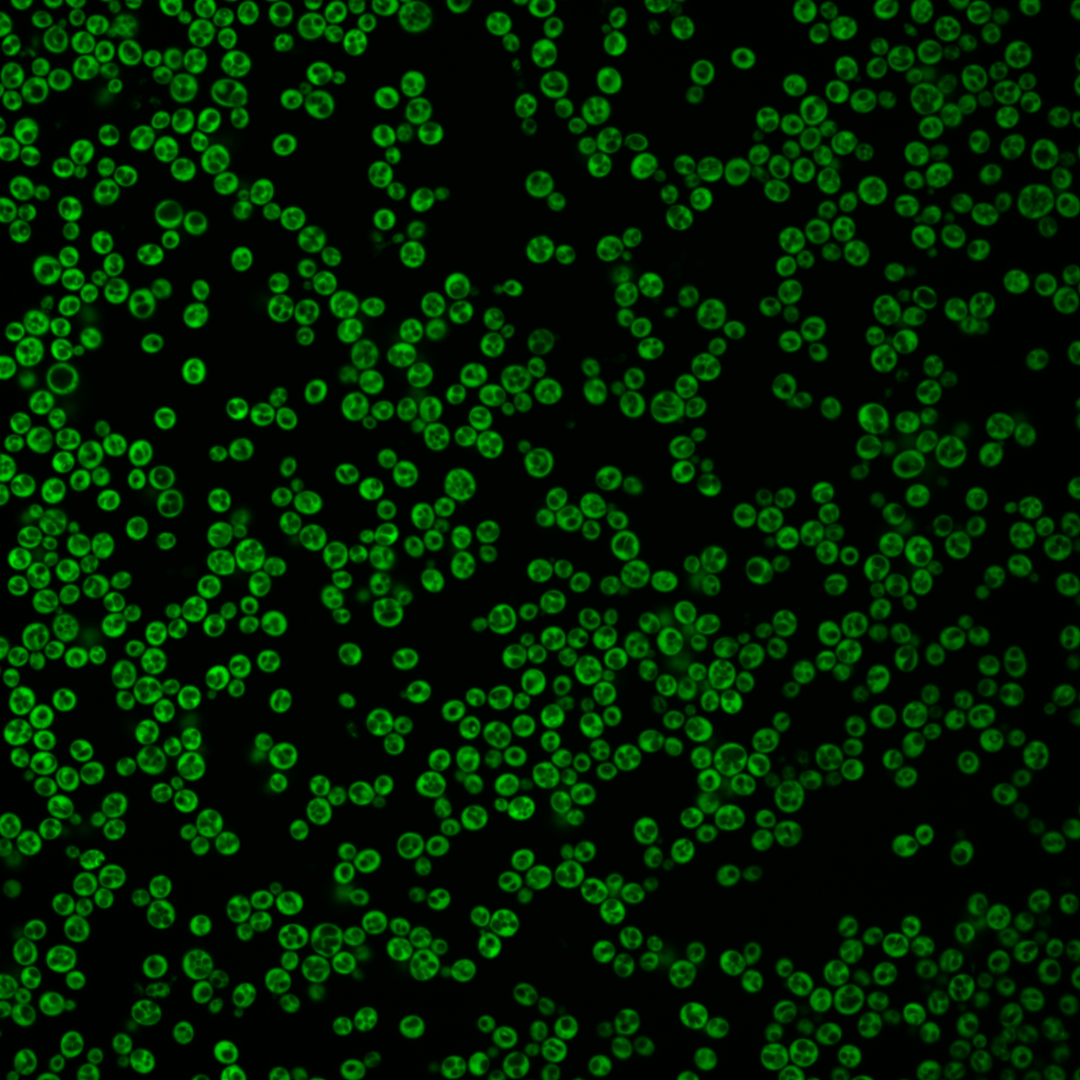
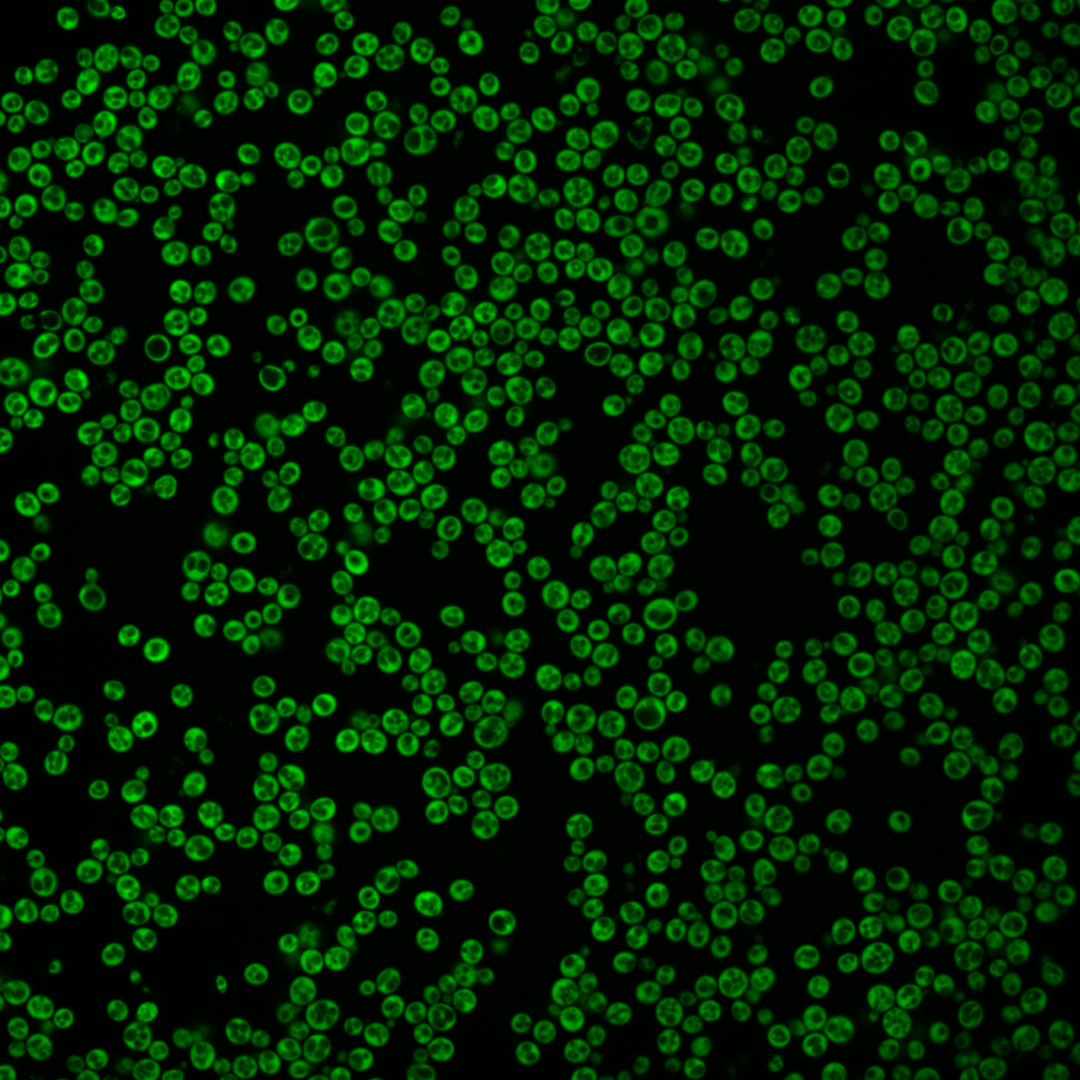
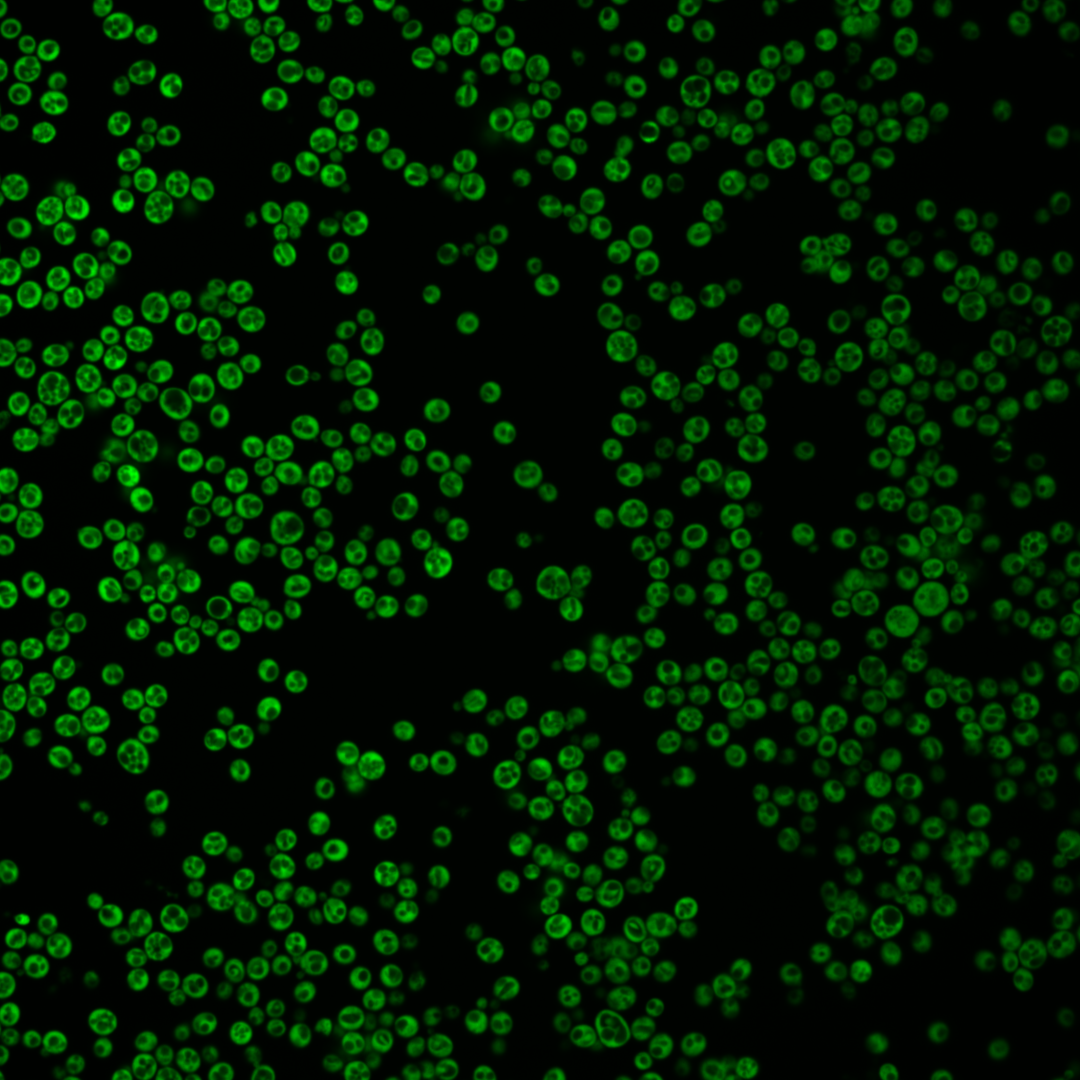
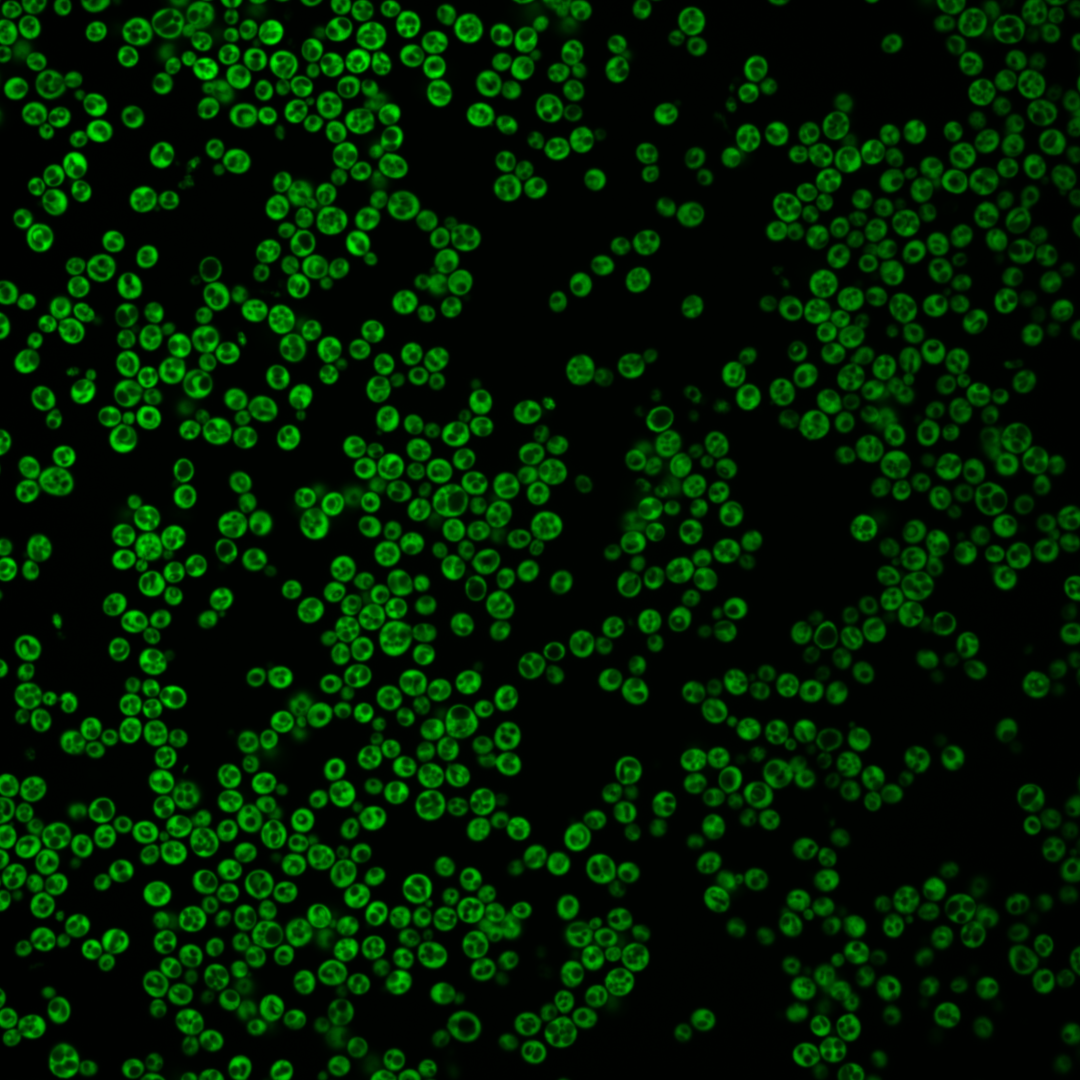

| Standard name | |
|---|---|
| Human Ortholog | |
| Description | Protein component of the small (40S) ribosomal subunit; mutation affects 20S pre-rRNA processing; homologous to mammalian ribosomal protein S4, no bacterial homolog; RPS4A has a paralog, RPS4B, that arose from the whole genome duplication |
Micrographs




















































































Sub-cellular Localization
Yeast GFP Assignment
Protein Abundance
Localization Change
External localization resources
| ensLOC | DeepLoc | |||||||||||||||||||||||
|---|---|---|---|---|---|---|---|---|---|---|---|---|---|---|---|---|---|---|---|---|---|---|---|---|
| Localization | WT1 | WT2 | WT3 | RAP60 | RAP140 | RAP220 | RAP300 | RAP380 | RAP460 | RAP540 | RAP620 | RAP700 | HU80 | HU120 | HU160 | rpd3Δ_1 | rpd3Δ_2 | rpd3Δ_3 | WT1 | WT2 | WT3 | AF100 | AF140 | AF180 |
| Cortical Patches | 0 | – | 0 | 0 | 0 | 0 | 3 | 1 | 3 | 7 | 4 | 13 | 0 | 0 | 0 | 0 | 0 | 0 | 0 | 0 | 0 | 0 | 0 | 0 |
| Bud | 0 | – | 0 | 0 | 0 | 0 | 1 | 0 | 1 | 2 | 0 | 0 | 0 | 0 | 0 | 0 | 0 | 0 | 0 | 0 | 0 | 2 | 2 | 6 |
| Bud Neck | 0 | – | 0 | 0 | 0 | 0 | 0 | 0 | 0 | 0 | 0 | 0 | 0 | 0 | 0 | 0 | 0 | 0 | 0 | 0 | 0 | 0 | 0 | 0 |
| Bud Site | 0 | – | 0 | 0 | 0 | 0 | 0 | 0 | 0 | 0 | 0 | 0 | 0 | 0 | 0 | 0 | 0 | 0 | – | – | – | – | – | – |
| Cell Periphery | 0 | – | 1 | 1 | 2 | 3 | 8 | 9 | 4 | 7 | 7 | 19 | 1 | 0 | 2 | 1 | 2 | 1 | 0 | 0 | 0 | 1 | 1 | 4 |
| Cytoplasm | 119 | – | 15 | 74 | 109 | 39 | 86 | 97 | 66 | 76 | 62 | 80 | 91 | 68 | 104 | 90 | 88 | 135 | 122 | 27 | 20 | 78 | 100 | 102 |
| Endoplasmic Reticulum | 0 | – | 0 | 1 | 4 | 1 | 16 | 6 | 11 | 10 | 10 | 20 | 1 | 0 | 1 | 4 | 7 | 8 | 1 | 0 | 0 | 2 | 0 | 5 |
| Endosome | 0 | – | 0 | 0 | 1 | 0 | 1 | 0 | 0 | 0 | 0 | 0 | 0 | 0 | 0 | 0 | 0 | 0 | 0 | 0 | 0 | 0 | 0 | 0 |
| Golgi | 0 | – | 0 | 0 | 0 | 0 | 1 | 1 | 3 | 6 | 1 | 2 | 0 | 0 | 0 | 0 | 0 | 0 | 0 | 0 | 0 | 0 | 0 | 0 |
| Mitochondria | 0 | – | 0 | 0 | 0 | 0 | 1 | 0 | 5 | 2 | 6 | 1 | 0 | 0 | 0 | 0 | 0 | 0 | 1 | 0 | 0 | 0 | 0 | 2 |
| Nucleus | 0 | – | 0 | 0 | 1 | 0 | 0 | 0 | 0 | 0 | 0 | 1 | 0 | 0 | 0 | 0 | 0 | 0 | 0 | 0 | 1 | 1 | 0 | 0 |
| Nuclear Periphery | 0 | – | 0 | 0 | 0 | 0 | 0 | 0 | 0 | 0 | 0 | 0 | 0 | 0 | 0 | 0 | 0 | 0 | 0 | 0 | 0 | 0 | 0 | 0 |
| Nucleolus | 0 | – | 0 | 0 | 0 | 0 | 1 | 0 | 0 | 0 | 0 | 1 | 0 | 0 | 0 | 0 | 0 | 0 | 0 | 0 | 0 | 0 | 0 | 0 |
| Peroxisomes | 0 | – | 0 | 0 | 0 | 0 | 0 | 0 | 0 | 0 | 0 | 0 | 0 | 0 | 0 | 0 | 0 | 0 | 0 | 0 | 0 | 0 | 0 | 0 |
| SpindlePole | 0 | – | 0 | 0 | 0 | 0 | 0 | 0 | 0 | 0 | 0 | 0 | 0 | 0 | 0 | 0 | 0 | 0 | 0 | 0 | 0 | 0 | 0 | 0 |
| Vac/Vac Membrane | 1 | – | 0 | 0 | 0 | 0 | 0 | 0 | 0 | 5 | 0 | 3 | 0 | 0 | 0 | 0 | 0 | 2 | 0 | 0 | 0 | 0 | 0 | 5 |
| Unique Cell Count | 120 | 16 | 76 | 115 | 42 | 114 | 110 | 83 | 105 | 81 | 120 | 92 | 68 | 105 | 90 | 89 | 138 | 130 | 30 | 24 | 89 | 109 | 132 | |
| Labelled Cell Count | 120 | 16 | 76 | 117 | 43 | 118 | 114 | 93 | 115 | 90 | 140 | 93 | 68 | 107 | 95 | 97 | 146 | 130 | 30 | 24 | 89 | 109 | 132 | |
Yeast GFP Assignment
Protein Abundance
| Screen | WT1 | WT2 | WT3 | RAP60 | RAP140 | RAP220 | RAP300 | RAP380 | RAP460 | RAP540 | RAP620 | RAP700 | HU80 | HU120 | HU160 | rpd3Δ_1 | rpd3Δ_2 | rpd3Δ_3 | AF100 | AF140 | AF180 |
|---|---|---|---|---|---|---|---|---|---|---|---|---|---|---|---|---|---|---|---|---|---|
| Mean Cell GFP Intensity (1e-4) | 146.1 | – | 117.7 | 121.4 | 93.0 | 61.7 | 58.2 | 57.9 | 45.5 | 47.5 | 44.2 | 43.6 | 139.5 | 145.7 | 151.6 | 238.0 | 305.2 | 301.0 | 127.5 | 122.7 | 122.1 |
| Std Deviation (1e-4) | 36.2 | – | 37.1 | 41.8 | 38.2 | 25.3 | 23.8 | 20.5 | 19.3 | 18.1 | 13.7 | 12.3 | 40.2 | 44.3 | 37.8 | 69.9 | 71.5 | 89.1 | 41.7 | 54.3 | 60.6 |
| Intensity Change (Log2) | – | – | – | 0.04 | -0.34 | -0.93 | -1.02 | -1.02 | -1.37 | -1.31 | -1.41 | -1.43 | 0.25 | 0.31 | 0.37 | 1.02 | 1.37 | 1.35 | 0.12 | 0.06 | 0.05 |
Localization Change
| Localization | RAP60 | RAP140 | RAP220 | RAP300 | RAP380 | RAP460 | RAP540 | RAP620 | RAP700 | HU80 | HU120 | HU160 | rpd3Δ_1 | rpd3Δ_2 | rpd3Δ_3 |
|---|---|---|---|---|---|---|---|---|---|---|---|---|---|---|---|
| Cortical Patches | 0 | 0 | 0 | 0 | 0 | 0 | 0 | 0 | 0 | 0 | 0 | 0 | 0 | 0 | 0 |
| Bud | 0 | 0 | 0 | 0 | 0 | 0 | 0 | 0 | 0 | 0 | 0 | 0 | 0 | 0 | 0 |
| Bud Neck | 0 | 0 | 0 | 0 | 0 | 0 | 0 | 0 | 0 | 0 | 0 | 0 | 0 | 0 | 0 |
| Bud Site | 0 | 0 | 0 | 0 | 0 | 0 | 0 | 0 | 0 | 0 | 0 | 0 | 0 | 0 | 0 |
| Cell Periphery | 0 | 0 | 0 | 0 | 0 | 0 | 0 | 0 | 0 | 0 | 0 | 0 | 0 | 0 | 0 |
| Cytoplasm | 0.7 | 0.2 | -0.1 | -1.6 | -0.7 | -1.4 | -1.8 | -1.6 | -2.2 | 1.4 | 2.1 | 1.5 | 2.4 | 1.4 | 1.0 |
| Endoplasmic Reticulum | 0 | 0 | 0 | 0 | 0 | 0 | 0 | 0 | 0 | 0 | 0 | 0 | 0 | 0 | 0 |
| Endosome | 0 | 0 | 0 | 0 | 0 | 0 | 0 | 0 | 0 | 0 | 0 | 0 | 0 | 0 | 0 |
| Golgi | 0 | 0 | 0 | 0 | 0 | 0 | 0 | 0 | 0 | 0 | 0 | 0 | 0 | 0 | 0 |
| Mitochondria | 0 | 0 | 0 | 0 | 0 | 0 | 0 | 0 | 0 | 0 | 0 | 0 | 0 | 0 | 0 |
| Nucleus | 0 | 0 | 0 | 0 | 0 | 0 | 0 | 0 | 0 | 0 | 0 | 0 | 0 | 0 | 0 |
| Nuclear Periphery | 0 | 0 | 0 | 0 | 0 | 0 | 0 | 0 | 0 | 0 | 0 | 0 | 0 | 0 | 0 |
| Nucleolus | 0 | 0 | 0 | 0 | 0 | 0 | 0 | 0 | 0 | 0 | 0 | 0 | 0 | 0 | 0 |
| Peroxisomes | 0 | 0 | 0 | 0 | 0 | 0 | 0 | 0 | 0 | 0 | 0 | 0 | 0 | 0 | 0 |
| SpindlePole | 0 | 0 | 0 | 0 | 0 | 0 | 0 | 0 | 0 | 0 | 0 | 0 | 0 | 0 | 0 |
| Vacuole | 0 | 0 | 0 | 0 | 0 | 0 | 0 | 0 | 0 | 0 | 0 | 0 | 0 | 0 | 0 |
External localization resources
Images






























Protein Concentration and Protein Localization Data
| R1 | R2 | R3 | ||||||||||||||||
|---|---|---|---|---|---|---|---|---|---|---|---|---|---|---|---|---|---|---|
| G1 Pre-START | G1 Post-START | S/G2 | Metaphase | Anaphase | Telophase | G1 Pre-START | G1 Post-START | S/G2 | Metaphase | Anaphase | Telophase | G1 Pre-START | G1 Post-START | S/G2 | Metaphase | Anaphase | Telophase | |
| Concentration | 173.4114 | 243.9982 | 219.4856 | 152.7077 | 176.0452 | 167.5323 | 191.7582 | 253.9583 | 211.6907 | 211.3036 | 250.7893 | 175.7368 | 154.7422 | 237.8715 | 242.9908 | 189.1348 | 193.424 | 211.2025 |
| Actin | 0.0061 | 0.0007 | 0.0033 | 0.0076 | 0.0013 | 0.0173 | 0.0068 | 0.0006 | 0.0066 | 0.0009 | 0.0005 | 0.0058 | 0.0489 | 0.0027 | 0.0025 | 0.0004 | 0.0769 | 0.0107 |
| Bud | 0.0039 | 0.0023 | 0.0044 | 0.0039 | 0.0054 | 0.0051 | 0.0031 | 0.0017 | 0.0042 | 0.002 | 0.005 | 0.0137 | 0.0068 | 0.0038 | 0.0088 | 0.002 | 0.0117 | 0.0102 |
| Bud Neck | 0.0012 | 0.0012 | 0.0013 | 0.0008 | 0.0012 | 0.0061 | 0.0043 | 0.001 | 0.0013 | 0.0011 | 0.0019 | 0.0019 | 0.0017 | 0.0027 | 0.0009 | 0.0004 | 0.0014 | 0.0025 |
| Bud Periphery | 0.0058 | 0.0019 | 0.004 | 0.0036 | 0.0027 | 0.0044 | 0.0038 | 0.0009 | 0.0036 | 0.0014 | 0.0074 | 0.0077 | 0.0108 | 0.0019 | 0.0029 | 0.0026 | 0.0112 | 0.0203 |
| Bud Site | 0.0032 | 0.0019 | 0.0019 | 0.0024 | 0.0005 | 0.001 | 0.0027 | 0.0015 | 0.0036 | 0.0009 | 0.0006 | 0.0028 | 0.0055 | 0.0047 | 0.0033 | 0.0006 | 0.0028 | 0.0006 |
| Cell Periphery | 0.0976 | 0.0571 | 0.0554 | 0.0464 | 0.01 | 0.0455 | 0.0834 | 0.0385 | 0.0477 | 0.0738 | 0.049 | 0.0226 | 0.0748 | 0.0452 | 0.0306 | 0.0644 | 0.0271 | 0.0093 |
| Cytoplasm | 0.3522 | 0.7162 | 0.627 | 0.3181 | 0.5646 | 0.4007 | 0.5098 | 0.8054 | 0.6033 | 0.4898 | 0.5014 | 0.4197 | 0.4265 | 0.7915 | 0.7049 | 0.2787 | 0.2635 | 0.4174 |
| Cytoplasmic Foci | 0.0136 | 0.0016 | 0.0088 | 0.0041 | 0.0754 | 0.0063 | 0.0031 | 0.0011 | 0.0052 | 0.0191 | 0.0019 | 0.0036 | 0.0149 | 0.0042 | 0.0031 | 0.0012 | 0.0049 | 0.0057 |
| Eisosomes | 0.0021 | 0.0001 | 0.0003 | 0.001 | 0.0021 | 0.0005 | 0.0013 | 0.0001 | 0.0004 | 0.0006 | 0 | 0.0049 | 0.0027 | 0.0006 | 0.0013 | 0.0001 | 0.0007 | 0.0003 |
| Endoplasmic Reticulum | 0.0294 | 0.0045 | 0.007 | 0.0104 | 0.0046 | 0.018 | 0.0292 | 0.0034 | 0.0037 | 0.002 | 0.0029 | 0.0086 | 0.0194 | 0.0025 | 0.0047 | 0.0006 | 0.0132 | 0.0419 |
| Endosome | 0.0213 | 0.0041 | 0.0144 | 0.0989 | 0.0086 | 0.0572 | 0.0135 | 0.0019 | 0.0121 | 0.0048 | 0.0054 | 0.0269 | 0.0064 | 0.0045 | 0.0034 | 0.0014 | 0.032 | 0.023 |
| Golgi | 0.0102 | 0.0006 | 0.0033 | 0.0076 | 0.0008 | 0.067 | 0.0024 | 0.0004 | 0.0032 | 0.0007 | 0.0002 | 0.0021 | 0.0027 | 0.0129 | 0.0005 | 0.0001 | 0.0196 | 0.0048 |
| Lipid Particles | 0.009 | 0.0027 | 0.0024 | 0.0129 | 0.0154 | 0.0025 | 0.0045 | 0.0014 | 0.0027 | 0.018 | 0.0017 | 0.0038 | 0.0067 | 0.0015 | 0.0025 | 0.0011 | 0.0036 | 0.0012 |
| Mitochondria | 0.0385 | 0.0022 | 0.0101 | 0.025 | 0.0542 | 0.0437 | 0.0134 | 0.0049 | 0.0113 | 0.0123 | 0.0009 | 0.0135 | 0.0424 | 0.0024 | 0.0143 | 0.0035 | 0.093 | 0.073 |
| None | 0.0093 | 0.0019 | 0.0056 | 0.0101 | 0.0151 | 0.0022 | 0.0044 | 0.0006 | 0.0105 | 0.0142 | 0.0005 | 0.004 | 0.0508 | 0.0014 | 0.0024 | 0.2001 | 0.0026 | 0.0032 |
| Nuclear Periphery | 0.0474 | 0.0066 | 0.0094 | 0.0391 | 0.0114 | 0.0086 | 0.0646 | 0.0083 | 0.0075 | 0.0161 | 0.0375 | 0.0565 | 0.0676 | 0.0145 | 0.0181 | 0.021 | 0.0356 | 0.0309 |
| Nucleolus | 0.023 | 0.0041 | 0.0066 | 0.0407 | 0.023 | 0.0021 | 0.005 | 0.0016 | 0.0042 | 0.026 | 0.0023 | 0.04 | 0.0113 | 0.0028 | 0.0079 | 0.0111 | 0.0103 | 0.0048 |
| Nucleus | 0.0192 | 0.0073 | 0.0089 | 0.026 | 0.0115 | 0.011 | 0.0249 | 0.0092 | 0.0119 | 0.0189 | 0.0222 | 0.114 | 0.0376 | 0.0155 | 0.0216 | 0.0305 | 0.0294 | 0.0222 |
| Peroxisomes | 0.0023 | 0.0002 | 0.0004 | 0.001 | 0.0041 | 0.0008 | 0.0003 | 0.0001 | 0.0003 | 0.0011 | 0.0001 | 0.0005 | 0.0012 | 0.0003 | 0.0008 | 0.0002 | 0.0011 | 0.0008 |
| Punctate Nuclear | 0.0009 | 0.0001 | 0.0013 | 0.0019 | 0.0016 | 0.0002 | 0.0008 | 0.0001 | 0.0002 | 0.0027 | 0.0001 | 0.0011 | 0.0027 | 0.0001 | 0.0002 | 0.0002 | 0.0004 | 0.0002 |
| Vacuole | 0.2317 | 0.1623 | 0.1827 | 0.2359 | 0.1262 | 0.24 | 0.1714 | 0.1009 | 0.2106 | 0.2287 | 0.2902 | 0.1427 | 0.1109 | 0.0704 | 0.1175 | 0.2116 | 0.1666 | 0.1353 |
| Vacuole Periphery | 0.072 | 0.0204 | 0.0416 | 0.1026 | 0.0604 | 0.06 | 0.0475 | 0.0165 | 0.0461 | 0.0648 | 0.0683 | 0.1035 | 0.0478 | 0.0141 | 0.0481 | 0.1683 | 0.1924 | 0.1817 |
Sequencing Data
| R1 | R2 | |||||||||
|---|---|---|---|---|---|---|---|---|---|---|
| G1 Post-START | S/G2 | Metaphase | Anaphase | Telophase | G1 Post-START | S/G2 | Metaphase | Anaphase | Telophase | |
| Gene Expression | 3092.6209 | 2990.5018 | 3110.2525 | 3462.5275 | 3426.3706 | 2228.0359 | 2912.9853 | 2756.3072 | 2709.009 | 3010.4452 |
| Translational Efficiency | 0.8452 | 0.8606 | 0.9183 | 0.6088 | 0.8682 | 1.1317 | 0.8755 | 0.8565 | 0.8723 | 0.9177 |
Hit Data
| Dataset | Hit |
|---|---|
| Protein Concentration | ✘ |
| Protein Localization | ✔ |
| Gene Expression | ✘ |
| Translational Efficiency | ✘ |
Endocytosis
| Temp | Actin Patch (Sac6-tdTomato) | Cortical Patch (Sla1-GFP) | Late Endosome (Snf7-GFP) | Vacuole (Vph1-GFP) |
|---|---|---|---|---|
| 37℃ | ||||
| RT |
Cell Cycle Omics
CYCLoPs (Rps4a-GFP)
| Gene / Allele | Actin Patch (Sac6-tdTomato) | Cortical Patch (Sla1-GFP) | Late Endosome (Snf7-GFP) | Vacuole (Sac6-tdTomato) |
|---|
| Gene | Images |
|---|
| Gene | Images |
|---|
Images are not yet available
Images are not yet available